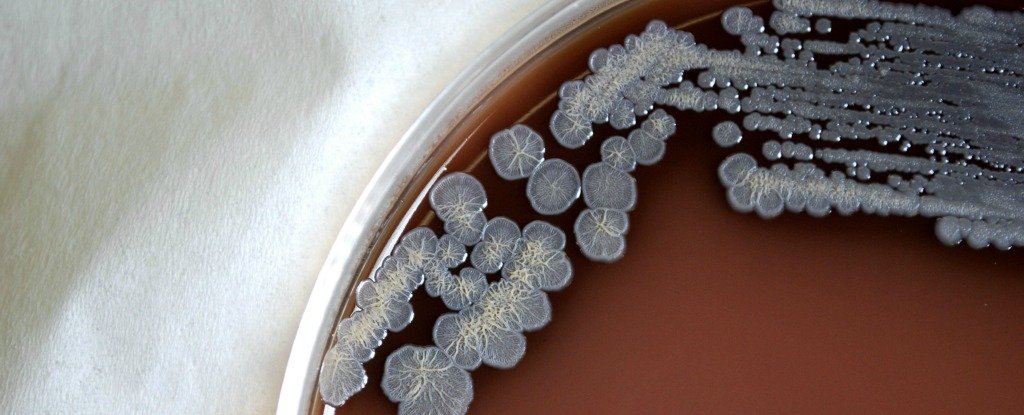

Trên quy mô toàn cầu chỉ tính riêng năm 2015, Melioidosis đã cướp đi sinh mạng của 90.000 người - chỉ thấp hơn con số 95.000 người tử vong bởi bệnh sởi.
Melioidosis (còn được gọi là bệnh Whitmore) là một loại bệnh lý rất ít được biết đến nhưng mỗi năm nó cướp đi sinh mạng của hơn 90.000 người và 70% bệnh nhân mắc phải sẽ cầm chắc "tấm vé đi gặp Tử Thần". Bên cạnh đó, căn bệnh này có thể chống lại hầu hết các loại kháng sinh hiện nay và nhiều người nhận định nó có đủ tiềm năng để sử dụng như một thứ vũ khí sinh học. Vậy tại sao nó không hề thu hút một sự chú ý nhất định nào? Đó chính là điều mà nghiên cứu của các nhà khoa học tại đại học Oxford (Anh) và đại học Mahidol (Thái Lan) muốn đề cập.

Được biết đến từ khoảng 100 năm trước, Melioidosis là một bệnh nhiễm khuẩn ở người hoặc động vật được gây ra bởi trực khuẩn Burkholderia pseudomallei. Thường được tìm thấy ở môi trường nhiệt đới, trực khuẩn Burkholderia pseudomallei có thể tồn tại tới 6 năm ở điều kiện tự nhiên và thậm chí nó có thể xâm nhập vào các nguồn nước. Bên cạnh đó, các nhà khoa học cho biết vi khuẩn Burkholderia pseudomallei xuất hiện thường trực ở hơn 34 quốc gia có khí hậu nhiệt đới, đặc biệt là khu vực Đông Nam Á và phía bắc Australia. Việt Nam tuy nằm trong vùng dịch tễ của bệnh nhưng các báo cáo về bệnh Melioidosis còn hạn chế.
Con người có thể mắc bệnh Melioidosis khi tiếp xúc trực tiếp với đất và nước bề mặt bị nhiễm vi khuẩn Burkholderia pseudomallei. Người và động vật có thể nhiễm khuẩn mắc phải do hít phải hạt nước hoặc bụi có nhiễm vi khuẩn, uống nguồn nước nhiễm khuẩn hoặc tiếp xúc trực tiếp với đất nhiễm khuẩn, đặc biệt là qua xây xước nhỏ ngoài da. Bệnh rất khó lây từ người sang người. Điểm đặc biệt của Melioidosis là không có vaccine hay loại kháng sinh nào để hạn chế tác động của nó đối với người bệnh, đây là lý do vì sao Trung tâm phòng ngừa và kiểm soát dịch bệnh Hoa Kỳ (CDC) lại xếp trực khuẩn Burkholderia pseudomallei vào nhóm vũ khí sinh học tiềm năng.
Ngoài ra, các triệu chứng của Melioidosis thường rất giống với nhiều loại bệnh khác do vậy có thể bị bỏ sót hoặc chẩn đoán nhầm với bệnh lao và các bệnh lý viêm phổi thông thường, chính vì thế rất nhiều bác sỹ trên thế giới đã đặt cho nó biệt danh "kẻ bắt chước đại tài". Các thể bệnh thường gặp của Melioidosis là: viêm phổi, nhiễm khuẩn huyết, nhiễm trùng cơ, nhiễm trùng phần mềm, viêm hạch, viêm xương... Thời kỳ ủ bệnh của Melioidosis đã được đánh giá ở một nghiên cứu duy nhất đã được công bố, theo đó thời gian ủ bệnh từ 1 đến 21 ngày (trung bình 9 ngày). Thời kỳ ủ bệnh ngắn nhất được ghi nhận là 1 ngày, trái lại thời kỳ ủ bệnh dài nhất đã ghi nhận được là 62 năm.

Chuyên gia vi sinh học Bart Currie đến từ Trường đại học Y Menzies (Australia) cho biết ngay cả khi bệnh nhân được chẩn đoán chính xác, việc điều trị cũng hết sức khó khăn vì phải dùng kháng sinh (thường là thuốc ceftazidime, kháng sinh cephalosporin thế hệ 3) tiêm liều cao kéo dài liên tục trong ít nhất khoảng 2 tuần, sau đó dùng kháng sinh duy trì khoảng từ 3 đến 6 tháng nữa. Điều nguy hiểm là bệnh dễ tái phát, sức khỏe của bệnh nhân rất dễ suy kiệt do bệnh tái đi tái lại hoặc nếu điều trị không đúng phác đồ. Ngoài ra, việc điều trị bệnh phải mất nhiều thời gian và tốn kém nên không ít bệnh nhân không có đủ khả năng để theo điều trị đến cùng. Đây là những nguyên nhân gây thất bại điều trị và tử vong.
Tác giả chính của nghiên cứu này, nhà sinh học Direk Limmathurotsakul cho biết khi thực hiện khảo sát để nghiên cứu tại Indonesia và Thái Lan thì ông đã không hề ngạc nhiên trước những số liệu thống kê về loại vi khuẩn chết người này vì nó cũng giống như những gì ông dự đoán trước đó. Thậm chí, ông thống kê được cứ 2 đến 3 bệnh nhân tử vong mỗi ngày vì Melioidosis trong mùa mưa tại miền Bắc Thái Lan. Trên quy mô toàn cầu chỉ tính riêng năm 2015, Melioidosis đã cướp đi sinh mạng của 90.000 người - chỉ thấp hơn con số 95.000 người tử vong bởi bệnh sởi. Ngoài ra, sự nguy hiểm của căn bệnh này còn đến từ việc trực khuẩn Burkholderia pseudomallei có thể tồn tại tới 16 năm trong nước cất nếu không có ai tiêu diệt chúng - điều này khiến việc kiểm soát sự lây lan lại càng trở nên phức tạp hơn.
Hiện tại, những bệnh nhân tiểu đường, có bệnh lý liên quan đến thận hoặc ung thư nằm trong danh sách những đối tượng dễ bị nhiễm trực khuẩn Burkholderia pseudomallei. Mặc dù vậy, những người khỏe mạnh vẫn có nguy cơ không hề nhỏ rơi vào danh sách bệnh nhân của Melioidosis. Bên cạnh đó, Direk Limmathurotsakul cũng khẳng định mặc dù nguy cơ nhiễm của trực khuẩn Burkholderia pseudomallei là không hề nhỏ nhưng nếu phòng tránh đúng cách thì mọi chuyện sẽ không đáng lo, ví dụ như những người sống ở khu vực nhiệt đới có thể mang thêm ủng hay găng tay mỗi khi ra ngoài vào mùa mưa, hoặc nếu có bị thương ngoài da thì nên hạn chế tiếp xúc với đất và nước bẩn.
Với nghiên cứu này, các nha khoa học hy vọng các cơ quan y tế sẽ chú ý hơn về căn bệnh nguy hiểm nhưng "ẩn mình" cực tốt này khi mà một trong những yếu tố thuận lợi để nó tiến vào bên trong cơ thể con người là bệnh tiểu đường đang trở thành một vấn đề nóng hiện nay. Bên cạnh đó, các nhà nghiên cứu cũng khẳng định nếu được quan tâm và điều trị đúng mức thì tỷ lệ tử vong sẽ giảm xuống còn con số 10%, thậm chí đa số bệnh nhân ở độ tuổi trưởng thành có thể sống sót nếu bị mắc phải.
Tham khảo Iflscience, ScienceAlert
NỔI BẬT TRANG CHỦ
-
Nhờ BIOS do Claude viết, chip Intel Bartlett Lake 12 P-core lần đầu chạy được trên bo mạch Z790 - nhưng vẫn chưa boot hoàn toàn
Lần đầu tiên Core 9 273PQE - chip Bartlett Lake 12 P-core - hiển thị đúng tên trên màn hình POST bo mạch Z790, nhờ firmware tùy chỉnh do Claude viết.
-
Sau nhiều năm bị chê viền dày, Google Pixel 11 cho thấy Google đã "lắng nghe"